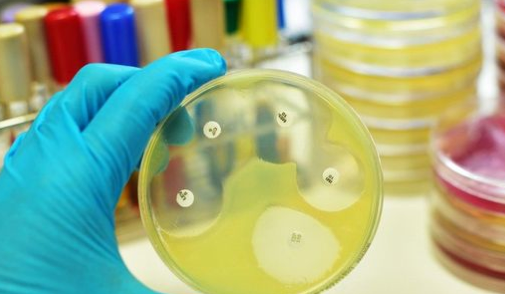

L’antibiorésistance pourrait devenir l’une des principales causes de mortalité dans le monde. Chaque année en France, 12 500 décès sont liés à une infection à bactérie résistante aux antibiotiques. À l’échelle mondiale, les résistances microbiennes seraient actuellement responsables de 700 000 morts par an. L’accroissement des résistances bactériennes et l’émergence de nouveaux mécanismes de résistance, remettent en question la capacité à soigner les infections, même les plus courantes. Ce phénomène, lié à la surconsommation et le mésusage des antibiotiques, est aggravé par l’arrêt de production de certains anciens antibiotiques et l’absence d’innovation depuis deux décennies, conduisant à une réduction de l’arsenal thérapeutique disponible.
L’antibiorésistance est un problème universel qui nécessite une action coordonnée associant santé humaine, animale et environnement. L’Organisation Mondiale de la Santé (OMS) a adopté en mai 2015 un plan d’action global, recommandant aux Etats membres d’élaborer un plan national sous le concept d’une seule santé, « One Health ». L’Union Européenne a adopté en juin 2016 une résolution visant à renforcer l’action des Etats membres. Au niveau international, une résolution a été adoptée récemment par l’Assemblée générale des Nations Unies.
L’antibiorésistance est un problème universel qui nécessite une action coordonnée associant santé humaine, animale et environnement. L’Organisation Mondiale de la Santé (OMS) a adopté en mai 2015 un plan d’action global, recommandant aux Etats membres d’élaborer un plan national sous le concept d’une seule santé, « One Health ». L’Union Européenne a adopté en juin 2016 une résolution visant à renforcer l’action des Etats membres. Au niveau international, une résolution a été adoptée récemment par l’Assemblée générale des Nations Unies.
40 actions réparties en 13 mesures phares
Le Gouvernement a souhaité intensifier la politique de maîtrise de l’antibiorésistance menée depuis les années 2000, à travers plusieurs plans ministériels qui ont permis d’atteindre de bons premiers résultats, en particulier en médecine vétérinaire.
À la demande du Premier ministre, le premier Comité Interministériel pour la Santé consacré à l’antibiorésistance a permis de définir une feuille de route gouvernementale composée de 40 actions réparties en 13 mesures phares, visant à diminuer la consommation d’antibiotiques de 25% d’ici 2018 et à réduire les conséquences sanitaires et environnementales de l’antibiorésistance.
Sensibilisation et communication auprès du grand public et des professionnels de santé : lancement d’un programme de sensibilisation à la prévention de l’antibiorésistance. L’accent sera notamment porté sur l’éducation pour la santé des jeunes et l’information des propriétaires d’animaux.
Formation des professionnels de santé et bon usage des antibiotiques en médecine humaine et vétérinaire : amélioration de la formation des professionnels de santé au bon usage des anti-infectieux ; renforcement de l’encadrement de la prescription des antibiotiques ; modification des conditionnements de ces médicaments afin d’insérer un message de mise en garde et de mieux les adapter aux durées de traitement ; développement des mesures de prévention, en particulier la vaccination.
Recherche et innovation en matière de maîtrise de l’antibiorésistance : développement de nouvelles stratégies thérapeutiques ; renforcement de la coordination des financements publics et des projets ; mise en œuvre d’une politique proactive de partenariats public-privé et d’accompagnement de l’innovation ; mise en place d’un comité technique de l’antibiorésistance afin de valoriser les nouvelles technologies, de préserver les anciennes, et d’améliorer leur mise à disposition des professionnels de médecine humaine et vétérinaire.
Mesurer et surveiller l’antibiorésistance : renforcement des réseaux de surveillance, notamment sur la présence de résidus dans l’environnement, pour contribuer à développer de nouveaux indicateurs communs au niveau national et européen ; création d’un réseau de surveillance en s’appuyant sur des structures françaises existantes, en collaboration avec l’OMS et l’Organisation mondiale de la santé animale (OIE).
Parallèlement, les positions de la France seront portées au niveau européen et international par le Ministère en charge des affaires étrangères, afin notamment d’interdire universellement l’usage des antibiotiques en tant que promoteurs de croissance en élevage, et de porter au niveau européen un projet de mécanisme d’encadrement spécifique, associé à un modèle économique soutenable, pour le développement de nouveaux produits.
À la demande du Premier ministre, le premier Comité Interministériel pour la Santé consacré à l’antibiorésistance a permis de définir une feuille de route gouvernementale composée de 40 actions réparties en 13 mesures phares, visant à diminuer la consommation d’antibiotiques de 25% d’ici 2018 et à réduire les conséquences sanitaires et environnementales de l’antibiorésistance.
Sensibilisation et communication auprès du grand public et des professionnels de santé : lancement d’un programme de sensibilisation à la prévention de l’antibiorésistance. L’accent sera notamment porté sur l’éducation pour la santé des jeunes et l’information des propriétaires d’animaux.
Formation des professionnels de santé et bon usage des antibiotiques en médecine humaine et vétérinaire : amélioration de la formation des professionnels de santé au bon usage des anti-infectieux ; renforcement de l’encadrement de la prescription des antibiotiques ; modification des conditionnements de ces médicaments afin d’insérer un message de mise en garde et de mieux les adapter aux durées de traitement ; développement des mesures de prévention, en particulier la vaccination.
Recherche et innovation en matière de maîtrise de l’antibiorésistance : développement de nouvelles stratégies thérapeutiques ; renforcement de la coordination des financements publics et des projets ; mise en œuvre d’une politique proactive de partenariats public-privé et d’accompagnement de l’innovation ; mise en place d’un comité technique de l’antibiorésistance afin de valoriser les nouvelles technologies, de préserver les anciennes, et d’améliorer leur mise à disposition des professionnels de médecine humaine et vétérinaire.
Mesurer et surveiller l’antibiorésistance : renforcement des réseaux de surveillance, notamment sur la présence de résidus dans l’environnement, pour contribuer à développer de nouveaux indicateurs communs au niveau national et européen ; création d’un réseau de surveillance en s’appuyant sur des structures françaises existantes, en collaboration avec l’OMS et l’Organisation mondiale de la santé animale (OIE).
Parallèlement, les positions de la France seront portées au niveau européen et international par le Ministère en charge des affaires étrangères, afin notamment d’interdire universellement l’usage des antibiotiques en tant que promoteurs de croissance en élevage, et de porter au niveau européen un projet de mécanisme d’encadrement spécifique, associé à un modèle économique soutenable, pour le développement de nouveaux produits.